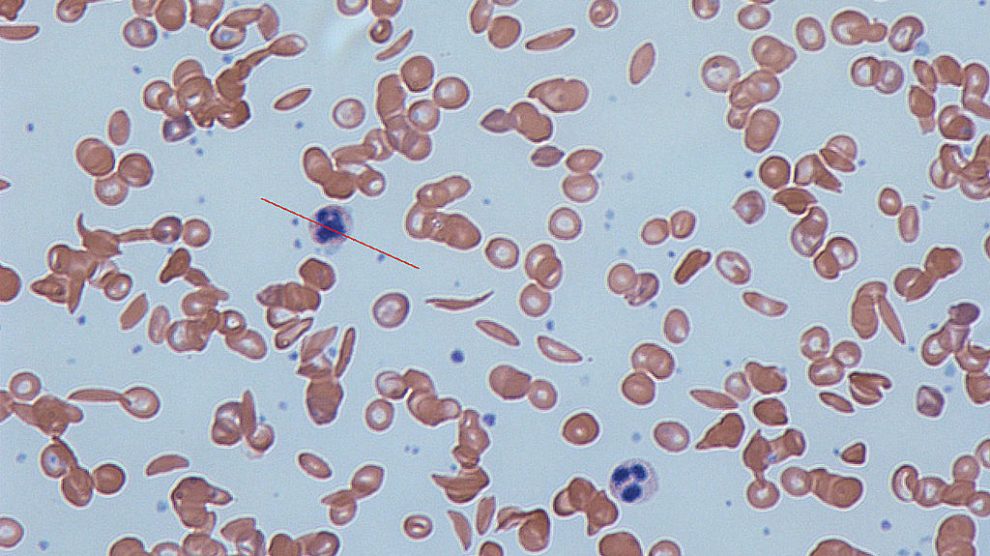

نجح الأطباء بشفاء مراهق فرنسي كان يعاني من مرض فقر الدم المنجلي عبر عكس المرض باستخدام طريقة علاج جديدة لتغيير حمضه النووي.
وأجريت العملية الأولى من نوعها في مستشفى “نيكر” للأطفال في فرنسا، وهي ستمنح الأمل لملايين المصابين بهذا المرض، بحسب موقع “بي بي سي”.
وقام الأطباء بتغيير التعليمات الجينية في النخاع العظمي للطفل، ما أدى إلى إنتاج خلايا دم حمراء صحية، وتبدو نتائج العملية إيجابية حتى الآن بعد 15 شهرًا من إجرائها، ولم يعد الطفل يتناول أي أدوية.
مرض فقر الدم المنجلي هو عبارة عن خلل وراثي في الدم، والتي يتميز بشكل غير طبيعي في جزيء الهيموجلوبين الذي يحمل الأوكسجين في خلايا الدم الحمراء. وهذا يؤدي إلى ميل طبيعي للخلايا لأن تكون غير طبيعية، جامدة، منجلية الشكل تحت ظروف معينة. ويرتبط مرض الخلية المنجلية مع عدد من المشاكل الصحية الحادة والمزمنة، مثل الالتهابات الحادة، أزمة الخلايا المنجلية، والسكتة الدماغية، وهناك خطر متزايد للموت.فقر الدم المنجلي هو أحد أنواع فقر الدم الانحلالي، الذي يصيب كريات الدم الحمراء. ويعد من أشهر أمراض الدم الوراثية الانحلالية، التي تسبب تكسر كريات الدم الحمراء، وهي اكثرها شيوعاً على مستوى العالم بشكل عام، وفي دول حوض البحر المتوسط والشرق الأوسط وأفريقيا والهند بشكل خاص. وهناك عدة أسماء لهذا المرض، فإضافة إلى فقر الدم المنجلي، يطلق عليه أيضًا اسم الانيميا المنجلية أو مرض المنجلية.
| خلايا الدم العادية القادمة لخلية المنجل |
ألمٌ قاتل
ويتسبب مرض فقر الدم المنجلي عادة بتغيير شكل خلايا الدم الحمراء، التي تحمل الأوكسجين حول الجسم من الدائري إلى شكل شبيه بالمنجل. وتمنع الخلايا المشوهة الجديدة الدم من الانتقال حول الجسم، ما يسبب ألمًا شديدًا، ويمكن أن تكون قاتلة في بعض الأحيان.
وكان الشاب الذي تلقى العلاج متضررًا لدرجة أن الاطباء اضطروا إلى إزالة طحاله واستبدال وركيه. وكان عليه أن يزور المستشفى مرتين في الشهر لتغيير دمه المصاب.
عندما كان الشاب يبلغ من العمر 13 عامًا، قام الأطباء بإزالة نخاع العظم الخاص به، الذي يسبب المرض، لتعديل الحمض النووي في المختبرات.
يحدث مرض الخلية المنجلية عندما يرث الشخص نسختين من الجين غير الطبيعي من “الهيموغلوبين” المسؤول عن حمل الأوكسجين في خلايا الدم الحمراء، واحد من كل من الوالدين.
| الفارق بين خلايا الدم العادية وبين الخلايا المنجلية |
باهظة الثمن
وتم حقن فيروس جديد في صيغة صنع “الهيموغلوبين” لتصحيح العيب، ومن ثم أعيد نخاع العظم إلى جسم المريض مرة أخرى. وبينت الأبحاث أن نخاع العظم بات يصنع دمًا طبيعيًا منذ 15 شهرًا، ولم يظهر أي علامة على المرض.
وأوضح الأطباء أنه يجب تطبيق طريقة العلاج الجديدة على العديد من المرضى، واختبارها مجددًا قبل إثبات فاعليتها بشكل كامل.
وعلى الرغم من أن العملية باهظة الثمن ولا تتم إلا في المستشفيات المتطورة والمختبرات، إلا أن غالبية المصابين بفقر الدم المنجلي موجودون في أفريقيا. ويكمن التحدي الأكبر في تحويل الطريقة الجديدة إلى “علاج” مثبت من شأنه أن يساعد وينقذ الملايين.

السلام عليكم
ممكن اعرف تكلفة العلاج
وشكرا